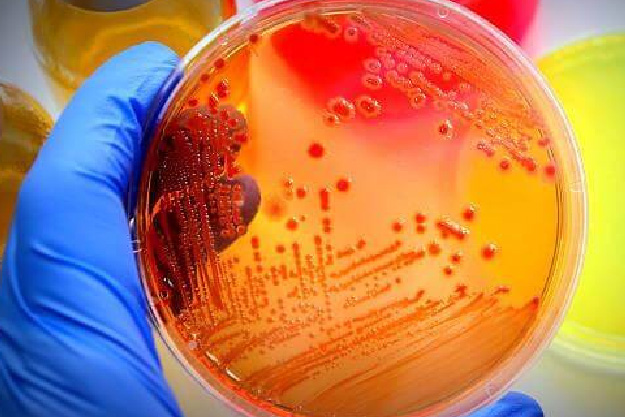

Com os crescentes avanços na área da saúde, diversos novos exames e tecnologias têm sido integrados à rotina laboratorial. Neste sentido, a Unijuí oferta a Especialização em Microbiologia Laboratorial que visa capacitar os profissionais sobre novas técnicas microbiológicas bem como suas interpretações e correlações clínicas.
A Pós-Graduação Lato Sensu é destinada a graduados em Biomedicina, Farmácia, Biologia, Medicina, demais profissionais da saúde e áreas afins. O curso conta com aulas teóricas e práticas, onde serão abordadas as principais alterações fisiopatológicas relacionadas às doenças microbiológicas; novas tecnologias e ensaios laboratoriais; e métodos de diagnóstico laboratorial.
As inscrições já estão abertas e podem ser realizadas até o dia 16 de abril, neste link. As aulas estão previstas para iniciar no dia 5 de maio, no campus Ijuí. Para mais informações sobre esta e outras especializações, acesse unijui.edu.br/estude/educacao-continuada/mba-e-especializacao ou entre em contato pelo telefone (55) 3332-0553, WhatsApp (55) 99180-6755 ou pelo e-mail estude@unijui.edu.br.